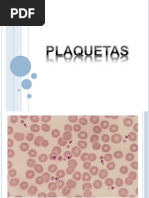

0% encontró este documento útil (0 votos)
142 vistas6 páginasResultados de Pruebas de Coagulación
El documento presenta los resultados de varias pruebas de coagulación realizadas a un paciente. Las pruebas muestran que los tiempos de coagulación son normales, lo que indica que los factores de las vías intrínseca, extrínseca y común no presentan déficit. La cuantificación de fibrinógeno arrojó un resultado ligeramente elevado, aunque esto podría deberse a la baja linealidad de la curva de calibración utilizada. No se detectaron monómeros de fibrina, descartando la presencia de hip
Cargado por
Oscar ArshavinDerechos de autor
© © All Rights Reserved
Nos tomamos en serio los derechos de los contenidos. Si sospechas que se trata de tu contenido, reclámalo aquí.
Formatos disponibles
Descarga como DOCX, PDF, TXT o lee en línea desde Scribd
0% encontró este documento útil (0 votos)
142 vistas6 páginasResultados de Pruebas de Coagulación
El documento presenta los resultados de varias pruebas de coagulación realizadas a un paciente. Las pruebas muestran que los tiempos de coagulación son normales, lo que indica que los factores de las vías intrínseca, extrínseca y común no presentan déficit. La cuantificación de fibrinógeno arrojó un resultado ligeramente elevado, aunque esto podría deberse a la baja linealidad de la curva de calibración utilizada. No se detectaron monómeros de fibrina, descartando la presencia de hip
Cargado por
Oscar ArshavinDerechos de autor
© © All Rights Reserved
Nos tomamos en serio los derechos de los contenidos. Si sospechas que se trata de tu contenido, reclámalo aquí.
Formatos disponibles
Descarga como DOCX, PDF, TXT o lee en línea desde Scribd